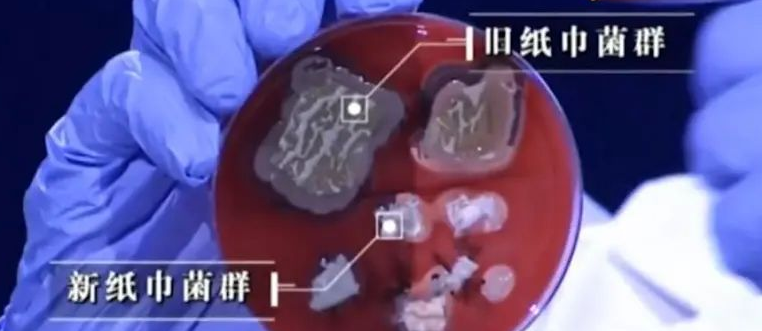
这种常见的卫生纸竟携带致病菌!看看你还在用吗?休闲区蓝鸢梦想 - Www.slyday.coM 这种常见的卫生纸竟携带致病菌!看看你还在用吗?休闲区蓝鸢梦想 - Www.slyday.coM

纸巾是我们每天都要亲密接触到的日用品,不管是吃完饭、流汗了、手脏了,还是上厕所,都会用到。出门更是要随身带一包,以防不时之需~
但你可知,卫生纸也有很多注意事项!

纸巾没用对,疾病找上门
1
买的纸巾本身不合格
去年,江苏市场监管局检查的多个品牌、150批次纸巾中,有36批次不合格,9批次的细菌总数超过国家标准的13倍。
(图片来源于网络截图)
这些不合格的纸巾,一方面可能生产环境脏、乱、差;另一方面也可能是原材料不合格。若长期使用劣质纸巾,轻则引起皮肤不适、炎症感染,重则诱发细胞加速增殖,有致癌风险。
2
开封久滞的纸巾是“最脏”的
几乎每位女性都会在包里放一小包纸巾,但这包纸巾很可能在包里待上好几个月,才会慢慢被用完。但你知道长时间开封的纸巾有多少细菌吗?
有节目曾就“开封的纸巾”做过一次实验——节目组将新买来的纸巾拿到实验室,现场开封取样,同时也提供了一份在口袋里携带了48小时的旧纸巾样本。
实验人员在旧纸巾上发现了大量的杆菌,杆菌就是我们肠道常见的寄生菌。
如果小孩或老人等体质较弱的人群长期使用这种纸张,有可能会影响身体健康,引起感染性疾病,出现腹泻、呕吐、发烧等症状。
因此,开了封在兜里、包里装了很久的纸巾,尽量不要再用了。
这三件事你也需要知道
1
餐巾纸和卫生纸,能混用?
早在2002年,卫生部便作出规定,明确禁止用卫生纸替代餐巾纸。两者的卫生标准和质量标准都不一样——
①卫生纸,俗称厕纸,生产标准为GB/T20810-2006,要求细菌菌落总数≤600cfu/g,真菌总数不受限定;

②餐巾纸,生产标准为:GB/T20808-2011,要求细菌菌落总数≤200cfu/g,真菌菌落总数≤100cfu/g。
餐巾纸规定只能使用木材、草类、竹子等原生纤维做原料,不能使用任何回收纸、纸张印刷品、纸制品和其他回收纤维状物质做原料。因此别再把卫生纸当餐巾纸了。
2
有香味的纸巾不安全?
合格的纸巾,是不会添加对人体有害的物质的。
也就是说,不管是有香味,还是有图案,只要符合国家标准,这类纸巾都不会有害健康。
不过,香味、颜料,确实都有引起过敏的可能。从健康的角度,这类纸巾不应该给小宝宝使用,大人最好也不好用来擦嘴或者上厕所,特别是敏感人群。

3
黄色纸比白色纸更好?
在日常生活中,可能很多人也都发现了黄色卫生纸价格偏贵,且主打的是纯天然、无危害。其实二者没有高下之分。
从原料上看,本色纸主要是秸秆造纸或竹浆;白色纸主要是木浆。
从制作工艺上看,本色纸比白色纸少了一道漂白的程序。
不过,正由于少了漂白的过程,这种纸浆的木质素含量较高,会使纸粗糙、发硬、沾水就烂。为了弥补这个缺陷,本色纸会添加更多的柔软剂和湿强剂;而白色纸多了漂白的程序,但相应的柔软剂和湿强剂的添加就少了。

需要说明的是:符合规范地使用漂白剂、柔软剂和湿强剂,并不会危害人体健康。所以按照自己的喜好、经济条件选择即可。
如何买到优质的纸巾?
1
购买时,看包装及成分
①选择符合国家标准的产品,包装上有执行标准编号,开头为GB/T。
②产品标有质量等级(优等品、一等品、合格品),在有条件的情况下,尽量选择优等品。
③生产日期和保质期在使用范围内。
④标有明确的生产单位、地址、联系方式等信息。

2
打开后,吸水性好、不掉粉尘
①浸泡
将购买回来的餐巾纸,拿出几张侵泡在水中,如果餐巾纸瞬间变碎,建议最好丢掉;
一般而言,优质的餐巾纸,即便被水侵泡,也不容易变碎,甚至从水中拿起后还是一张完整的纸。

②撕扯
直接撕扯餐巾纸,若是一扯就撕开,切裂口粗糙,甚至会掉“灰尘”,基本就可以确认是劣质纸巾;一般优质的纸巾抗拉强度较好、不会掉“灰尘”。

更多知识




